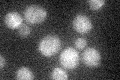
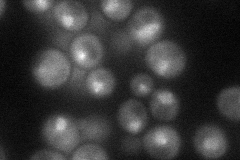
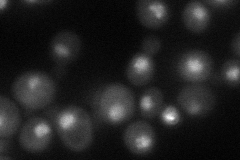
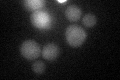

View description
DNA-binding transcription factor required for the activation of the GAL genes in response to galactose; repressed by Gal80p and activated by Gal3p
Localization:
Intensity:
Fold change:
Significance:
-
C’ GFP library in SD
cytosol19.46 -
N' NOP1pr-GFP in SD
punctate,nucleus49.7374 -
N' TEF2pr-mCherry in SD
punctate,nucleus44.6252 -
N' NATIVEpr-GFP in SD

nucleus28.6393 -
N' TEF2pr-VC and Cyto-VN in SD

punctate32.886 -
C’ GFP library in SD+DTT
cytosol16.280.83No -
C’ GFP library in SD+H2O2

cytosol18.910.97No -
C’ GFP library in Starvation Media

cytosol15.640.8No -
C’ GFP library on the background of Pup2-DaMP

cytosol -
C’ GFP library on the background of CCT mutant

cytosol17.5370.900975No
